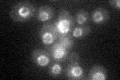
YLR450W
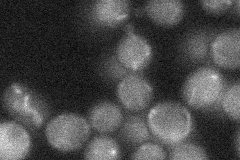
YLR450W
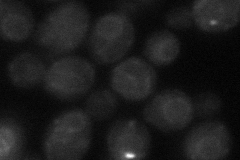
YLR450W
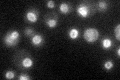
YLR450W

View description
One of two isozymes of HMG-CoA reductase that convert HMG-CoA to mevalonate, a rate-limiting step in sterol biosynthesis; overproduction induces assembly of peripheral ER membrane arrays and short nuclear-associated membrane stacks
Localization:
Intensity:
Fold change:
Significance:
-
C’ GFP library in SD
nuclear periphery28.13 -
N' NOP1pr-GFP in SD

ER101.053 -
N' TEF2pr-mCherry in SD

ER,nuclear periphery110.354 -
N' NATIVEpr-GFP in SD
below threshold18.8535 -
N' TEF2pr-VC and Cyto-VN in SD
ER34.1714 -
C’ GFP library in SD+DTT

nuclear periphery33.531.19No -
C’ GFP library in SD+H2O2

nuclear periphery37.451.33Yes -
C’ GFP library in Starvation Media
nuclear periphery41.341.46Yes -
C’ GFP library on the background of Pup2-DaMP

nuclear periphery -
C’ GFP library on the background of CCT mutant

nuclear periphery22.74120.808251No
